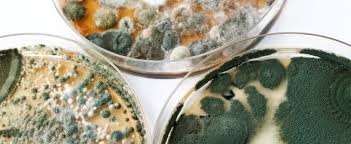

air duct cleaning deerfield beach

Sparkly Clean Maid Services! Cleaning houses and apartments.● Free estimates We deep cleaning of houses, apartments , offices and all kinds of business. Lucy Cleaning Service / Janitorial Services, Commercial & Residential Dehumidifying Service Flood Drying Company FT Lauderdale Pompano Beach FL Pembroke Pines Tamarac FL Dehumidifying Service Flood Drying Company Miami South Miami Beach Hialeah Homestead Coral Gables FL Dehumidifying Service Flood Drying Company Key West Key Largo Key Biscayne Marathon Islamorada FL Key West Junk Removal Garage Clean Out House Clean Out Hoarding Clean Out Key Largo Key Biscayne FL Miami Junk Removal Garage Clean Out Attic Cleanout House Clean Out Hoarding Clean Out In Miami FL West Palm Beach Junk Remove Garage Clean Out Attic Cleanout House Clean Out Hoarding Clean Out In FL Commercial Carpet Flood Damage Cleaning Miami Miami Beach Coral Gables Hialeah Sunny Isles FL Commercial Carpet Flood Damage Cleaning Florida Keys Key Largo Key West Key Biscayne Homestead FL

Empleadas Domesticas con amor a las mascotas area Miami BeachHome / Office Cleaning By Ana Carpet/ Rug Cleaning & Sanitizing, Air Duct Cleaning, & More! Carpet and Rug Cleaning Professionals ! ******POST Remodeling & More **** Cleaning Services********** 25 Year Old Maid Service - 954-797-8686 Broward County ★ ☆★Housecleaning- Limpieza de casas ■ □ ☆
kebaikan air purifier sharp Rodent Droppings Rat Mouse Poop Removal North West Palm Beach Lake Worth Delray Juno Beach Jupiter
apa guna air purifier Bat Rodent Droppings Rat Mouse Poop RemovalFt Lauderdale Pompano Deerfield Beach Boca Raton Dania FL
air purifier airvax Rodent Mice Droppings Rat Mouse Poop Removal Florida Keys Key Largo Key West Key Biscayne Marathon
Rodent Mice Droppings Rat Mouse Poop Removal Miami Beach Hollywood Hallandale Coral Gables Hialeah Bat Rodent Mice Droppings Rat Mouse Poop Removal South Beach Miami Beach North Miami Coconut Grove Bat Rodent Mice Droppings Rat Mouse Poop Removal Florida Keys Islamorada Big Pine Key Tavernier FL Bat Rodent Mice Droppings Rat Mouse Poop Removal Ft Lauderdale Beach Miramar Tamarac Plantation FL Bat Rodent Mice Droppings Rat Mouse Poop Removal WPB Royal Palm Beach Boynton Beach Riviera Beach FL Boca Raton Hoarding Cleanup Home House Clean Up Attic Garage Estate Clean Out Clutter Cleanout In FL Delray Beach Hoard Cleanup House Clean Up Attic Garage Estate Clean Out Clutter Cleanout Lake Worth Hialeah Hoarding Cleanup Home House Clean Up Attic Garage Estate Clean Out Clutter Cleanout Hialeah Ft Lauderdale Hoarding Cleanup Home House Clean Up Attic Garage Estate Clean Out Clutter Cleanout FL Riviera Beach Hoarding Cleanup House Clean Up Attic Garage Estate Clean Out Clutter Cleanout Jupiter

Are You Living With Dirty Carpets? Dirty Carpets, Rugs, or Upholstery? HOUSE BUTLER window cleaning Extraordinaria Limpieza Hogar u Oficina Profunda 3053671929 Select units on sale now---- ********** RESIDENTIAL Cleaning Services & MORE ********** Air Scrubber Desiccant Dehumidifier Rental Miami Coral Gables North MIami Kendall Perrine Doral FL Air Scrubber Desiccant Dehumidifier Rental Ft Lauderdale Plantation FL Coral Springs FL Margate FL Air Scrubber Desiccant Dehumidifier Rental West Palm Beach Lake Worth FL Riviera Beach FL Jupiter FL ◆◆◆Housecleaning - Limpieza de casas ■ □ ☆ Air Scrubber Desiccant Dehumidifier Rental Florida Keys Tavernier Big Pine Key Monroe County FL Keys Dehumidifying Service Flood Drying Company Florida Keys Tavernier Big Pine Key Monroe County FL Keys Dehumidifying Service Flood Drying Company West Palm Beach Lake Worth FL Riviera Beach FL Jupiter FL Dehumidifying Service Flood Drying Company Ft Lauderdale Plantation FL Coral Springs FL Margate FL

Dehumidifying Service Flood Drying Company Miami Coral Gables North MIami Kendall Perrine Doral FL Commercial Carpet Water Damage Cleaning North West Palm Beach Lake Worth Delray Juno Beach Jupiter Commercial Carpet Water Damage Cleaning Ft Lauderdale Pompano Deerfield Beach Boca Raton Dania FL Commercial Carpet Water Damage Cleaning Florida Keys Key Largo Key West Key Biscayne Marathon FL Commercial Carpet Water Damage Cleaning Miami Miami Beach Hollywood Hallandale Coral Gables Hialeah Storm Damage Repair Service in Sarasota County Water Damage Repair Service in Sarasota County Do you Suspect MOLD due to a Leak? Carpet & Rug Cleaning, Air Duct Cleaning, & More! Hago limpieza casas/ I doin clean house all aere close miami Call the CARPET and RUG CLEANING Professionals TODAY! $40 💜Best Maid Ever 💜 $50 💋Best Housekeeper Ever💋9543309633 Maid For You. The Residential AND Commercial Painting. ◆◇◆House cleaning - Limpieza de casas ● ○ ● Wpb

Spring Cleaning for private Home, Vacation Rental Homes, $15/h West Palm Beach Wet Carpet Removal West Palm Beach FL Attic Insulation Removal Animal Feces Removal Ft Lauderdale Wet Carpet Removal Ft Lauderdale Attic Insulation Removal Animal Feces Removal Delray Miami Wet Carpet Removal Miami FL Wet Attic Insulation Removal Animal Feces Removal Miami Beach FL Pompano Beach Wet Carpet Removal Pompano Beach Attic Insulation Removal Animal Feces Removal Pompano Coral Gables House Commercial Building Demolition Service Home Gut Out Shed Barn Garage Demo Hialeah Pompano Beach House Commercial Building Demolition Service Home Gut Out Shed Barn Garage Demo In FL Hallendale House Commercial Building Demolition Service Home Gut Out Shed Barn Garage Demo Margate Miami House Commercial Building Demolition Service Home Gut Out Shed Barn Garage Demo Miami Beach FL Ft Lauderdale House Commercial Building Demolition Service Home Gut Out Shed Barn Garage Demo Delray

West Palm Beach House Commercial Building Demolition Service Home Gut Out Shed Barn Garage Demo FL Hialeah Hoarding Junk Trash Removal Commercial Clutter Clean Out Barn Crawlspace Clean Up Hialeah FL Ft Lauderdale Hoarding Junk Trash Removal Commercial Clutter Clean Out Barn Crawlspace Clean Up FL Boca Raton Hoarding Junk Trash Removal Commercial Clutter Clean Out Barn Crawlspace Clean Up Boca Delray Hoarding Junk Trash Removal Commercial Clutter Clean Out Barn Crawlspace Clean Up Lake Worth Riviera Beach Hoarding Junk Removal Commercial Clutter Clean Out Barn Crawlspace Clean Up Jupiter FL ▐▐▐>BEST RATES + VETTED MAIDS = alphamaids 305 588 1226! CALL OR TEXT RIGHT NOW!!!! !305How to Find the Right and Best Auto Insurance Company for your Needs kristinas Cleaning Service !! Carpet & Rug Cleaning, Air Duct Cleaning, & More! Dirty Carpets, Rugs, or Upholstery? CallSparkly Clean Maid Services! Affordable, reliable, detailed. Same■□■Housecleaning - Limpieza de casas■□■